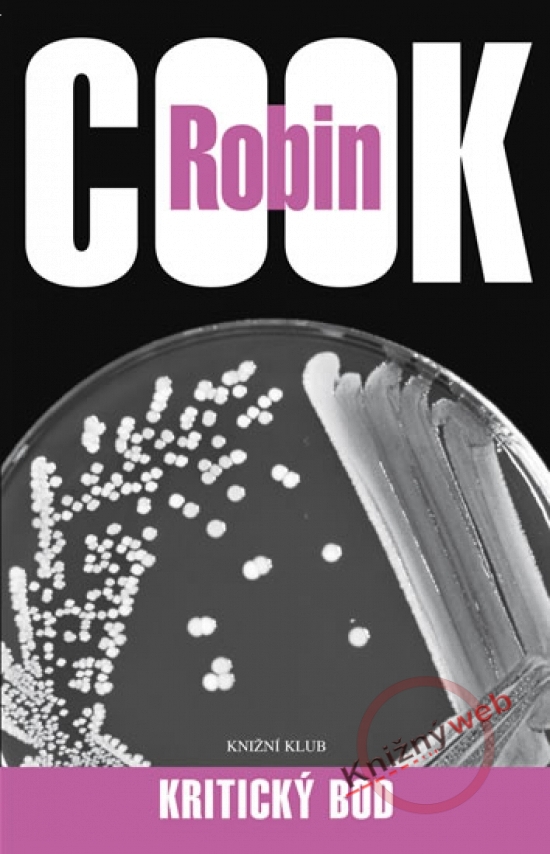
Obrázok Kritický bod

Katalóg kníh
Dobrodružstvo, napätie, fantasy
Umění truchlit - Případy soudce Ťi
Frédéric Lenormand
V provincii, která spadá pod správu soudce Ťi, se zařala šířit epidemie. Obyvatelé jsou přesvědčeni, že nákazu šíří mstící se duše oběšeného člověka. Soudci Ťi ...
EUR
Na dopyt
Virus
Robert Liparulo
Byl vytvořen seznam 10 000 jmen tak, aby byl zničující účinek co největší. Významní obchodníci, ženy v domácnosti, politikové, celebrity, domovníci, děti. Nikdo ...
EUR
Na dopyt
James Bond - Muž se zlatou zbraní
Ian Fleming
James Bond obdrží zprávu, která 007 označuje za další cíl "muže se zlatou zbraní". Francisco Scaramanga si pro své oběti nechává tavit kulky ze zlata a ze stejn ...
EUR
Na dopyt
Konečná diagnóza - Hailey
Arthur Hailey
Román Konečná diagnóza, vydaný v roce 1959, se stal prvním skutečným Haileyho bestsellerem. Autor svůj román umístil na oddělení, po jehož vyslovení většině z n ...
EUR
Na dopyt
Špion
Evžen Kulič
Špion. Letec. Voják. Kmenový vůdce. Milující otec. Dobrodruh… Tam někde dole pod rovníkem, kdesi až na druhé straně zeměkoule, leží Austrálie. Jedny z nejdraž ...
EUR
Na dopyt
Kritický bod
Robin Cook
Akciová společnost provozující síť luxusních klinik Angels Healthcare se chystá vstoupit na burzu. V nejnevhodnější chvíli se objevují komplikace - po klinikách ...
EUR
Na dopyt
LEVEL 26: Netvor z temnot
Zuiker Anthony E., Swierczynski Duane
Anthony E. Zuiker & Duane Swierczynski: Level 26 – Netvor z temnot Každého vraha na světě lze zařadit do některé z pětadvaceti kategorií podle míry spáchaného z ...
EUR
Na dopyt
Šest dnů Kondora
James Grady
Děj strhujícího románu se odehrává v oddělení CIA, kde mladý literární vědec Joe Turner a jeho splupracovníci kontrolují brakovou literaturu, aby odhalili přípa ...
EUR
Na dopyt
Proroctví - Poslední tajemství proslulého Nostradama
Chris Kuzneski
Poslední tajemství proslulého Nostradama Zdá se, že předpovědi věhlasného francouzského lékaře a astrologa z 16. století se začínají s děsivou přesností naplňov ...
EUR
Na dopyt
Zálesák - 3. vydání
Grey Zane Loren
Zálesák Milt Dale, vytržený z poklidného života v tichu horských lesů Divokého západu, se stane iniciátorem i svědkem vzrušujících událostí. Pomáhá přátelům v b ...
EUR
Na dopyt
Scarpettová
Patricia Cornwellová
Kay Scarpettová opustila soukromou forenzní patologickou praxi v Charlestonu a odjela do New Yorku, protože ji místní policie požádala, aby vyšetřila jednoho zr ...
EUR
Na dopyt
Dívka, která kopla do vosího hnízda
Stieg Larsson
Dva těžce zranění lidé byli přijati na pohotovost v nemocnici v Gotheburgu. Jedna z nich je hledaná vražedkyně Lisbeth Salanderová s kulkou v hlavě, která potře ...
EUR
Na dopyt
Zelená zóna - Velkolepý život ve Smaragdovém městě
Rajiv Chandrasekaran
Podkladem knihy jsou reportáže, rozhovory a vlastní zážitky dopisovatele Washington Post, který v Bagdádu žil téměř nepřetržitě od listopadu 2002 až do 30. září ...
EUR
Na dopyt
James Bond - Thunderball
Ian Fleming
Bondovka z roku 1961. V pořadí devátý slavný příběh neuvěřitelného agenta 007 Jamese Bonda. Organizace SPECTRE unese britský letoun s dvěma atomovými bombami, k ...
EUR
Na dopyt
Tak žádá Bůh
Jean-Michel Sakka
Vatikánem otřásl výbuch. V jednom tamějším muzeu došlo k sebevražednému atentátu. Podle vyšetřovatelů měl být usmrcen papež, ten však jako zázrakem vyvázl. Znám ...
EUR
Na dopyt
Akta Golgata - 2.vydání
Philipp Vandenberg
Přes kilo a půl tmavohnědé rosolovité tkáně -- lidská játra určená pro transplantaci… Pro profesora Gropiuse, vynikajícího chirurga z univerzitní kliniky v Mnic ...
EUR
Na dopyt
Ten neviditelný
Andrew Britton
Napětí mezi Pákistánem a Indií je na dosud nejvyšší úrovni. Aby byly věci ještě složitější, dvanáct amerických horolezců zmizelo v pákistánském pohoří Hindúkuš. ...
EUR
Na dopyt
Bez rizika
Patricia Cornwellová
Win Garano má další případ. Jeho nadřízená Monique Lamontová si ho opět vyžádala, aby za pomoci moderních forenzních vyšetřovacích metod vyřešil vraždu starou v ...
EUR
Na dopyt
Smrtelný pád
Robert Liparulo
Daleko v pustině Severozápadních teritorií se čtyři hrdinové knihy vydávají na cestu, jaká se podniká jednou za život. Hutch, Terry, Phil a David se nechají vy ...
EUR
Na dopyt
Ten Američan
Andrew Britton
Velice působivá prvotina jednoho z nejnovějších hlasů v oblasti napínavých příběhů. Andrew Britton vytvořil odvážný román, který praská vysokými sázkami, naléha ...
EUR
Na dopyt
Diplomatická imunita
Lois McMaster Bujold
Podrobnejšie informácie o knihe Diplomatická imunita: Kdesi ve vzdáleném koutě vesmíru obývaném rasou čtyřruček byla kvůli násilnému incidentu barrayarského důs ...
EUR
Na dopyt
Třetí stupeň
Greg Iles
Nejnovější thriller autora bestsellerů Grega Ilese je nezapomenutelný příběh plný sexu, násilí, manželské zrady, podvodné medicínské praxe a jižanských intrik.. ...
EUR
Na dopyt
Pozorovatelé
John Altman
Nebezpečná hra na kočku a myš mezi zatčeným teroristou, špičkovým psychiatrem a chladnokrevným nájemným vrahem. Na odlehlé farmě blízko kanadských hranic, která ...
EUR
Na dopyt
Klam
John Altman
Autor vynikajících románů Střet špionů a Hra špionů umístnil děj svého nového napínavého románu do současnoti. Hannah Grayová, která prchá před zákonem po neúmy ...
EUR
Na dopyt